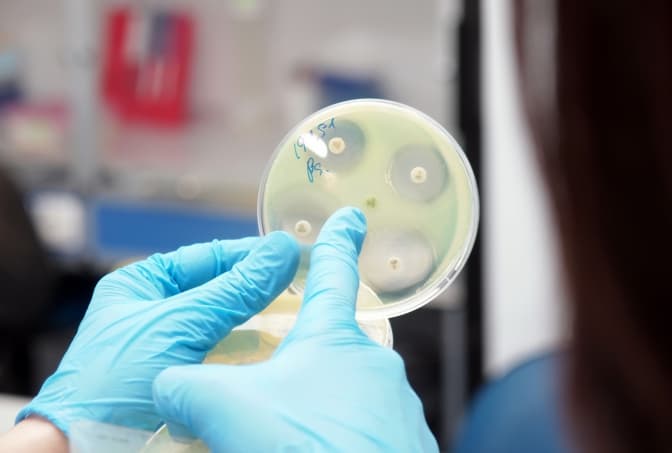

Аналіз крові – проста та водночас складна процедура. Із лабораторного центру – маніпуляційного кабінету – пробірка з матеріалом здійснює серйозну мандрівку для того, щоб результат був максимально точним, швидким та якісним.
Проста реєстрація – легка маніпуляція
Найбільш неприємним для мене є аналіз крові з вени. Як виявилось, саме його мені і потрібно здавати. У лабораторії, яку обрала – а це «Сінево» – є онлайн-реєстрація. Все просто і доступно. Після реєстрації мені на мобільний прийшов код, з яким звернулась на рецепцію.
Керівниця медичної лабораторії «Сінево» у Львові Галина Малиновська пояснює, що цей код вже містить інформацію, які аналізи потрібно зробити людині, якою має бути пробірка для аналізів. У лабораторії пробірку реєструють та присвоюють їй унікальний штрих-код.
Як додає Галина Малиновська, аналіз на глікований гемоглобін допомагає визначити наявність у людини цукрового діабету. Тут, у лабораторії, під час днів відкритих дверей кожен може поспостерігати за мандрівкою власної пробірки з кров’ю: як вона проходить сортування та потрапляє у прилад – аналізатор.
Далі для мене найстрашніше: слід пройти в маніпуляційну. Тут затишно і просторо. Зручна кушетка із симпатичним підлокітником. Медсестра звіряє дані та затискає руку вище ліктя кольоровим джгутом. Відвертаюсь від вигляду крові, пошуку вени голкою чи несамовитого болю. Лиш би не знепритомніти… а мені кажуть, що можу йти. Я навіть не відчула, коли у мене взяли кров, настільки непомітною була ця маніпуляція. На місце уколу наліплюють милий пластир та винагороджують батончиком гематогену.

Після того, як взяли аналіз, голки скидають у спеціальний контейнер, дезінфікують, знезаражують. Є спеціальна служба, яка забирає їх на утилізацію. Як розповіла мені Ольга Шкурпіта, медсестра лабораторії «Сінево», яка проводить забір аналізів, за увесь час її роботи людині стало погано лише раз: мала слабкий тиск і боялась вигляду крові.
Аналізи неможливо переплутати
У спеціальному контейнері медсестра відносить пробірку в лабораторію, далі її сканують в інформаційній системі «Сілаб». Під час сканування видно аналізатор, а також зрозуміло, на який прилад потрапить пробірка.
«Аналізи не сплутаєш», – коментує керівниця лабораторії. Коли людина здає кров, медсестра завжди має звірити пробірку. На ній наклеєно унікальний штрих-код. У лабораторії з пробірок штрих-коди не відклеюють, вони залишаються на них увесь час, а в процес аналізу працівники лабораторії не втручаються.

Менше стресу, більше інформації
Галина Малиновська впевнено веде мене лабораторією, розповідаючи подальшу долю моєї пробірки із кров’ю. У спеціальних термоконтейнерах матеріал розсортовують та складають по штативах.
Кожну пробірку з кров’ю обережно перевертають у руках кілька разів, бо усередині є речовина – антикоагулянт, яка не дає крові згорнутися. Лаборантка відкриває ковпачки і ставить пробірки у спеціальні штативи, а ті – в аналізатор. Опісля їх виймають, накривають новими ковпачками та переміщають в архів. Коли пацієнт здає один аналіз, наступного дня можна дозамовити й інший на ту саму кров, яку здав. Окремо оплачується лише послуга, кров здавати вже не потрібно. У лабораторії дивляться, чи все гаразд із пробіркою та її показниками, і доробляють потрібні аналізи.

Мандри пробірки
Найпопулярніший аналіз у «Сінево» – це загальний аналіз крові. Він є одним із простих й доступних методів обстеження всього організму, який дозволяє лікареві оцінити загальний стан здоров'я.
Є дослідження, які проводять на місці: це загальноклінічні дослідження, біохімія, гормони, онкомаркери і дослідження бак-посіву. Є тести, які не виконуються в місцевій лабораторії, а лише у центральній в Києві. Є й такі, що летять до лабораторії IMD в Німеччині. Відповідно, кожного дня логістична компанія транспортує пробірки до столиці у спеціальних контейнерах для біологічного матеріалу. Звідти двічі на тиждень матеріали відправляють до Німеччини. На даний момент в Україні є сім медичних лабораторій «Сінево» (центральна в Києві та шість регіональних) та 220 лабораторних центрів для взяття аналізів.
«Інколи пацієнти кажуть, що у цьому районі міста йому зробили аналіз краще, аніж в іншому. Кажуть це з нерозуміння, адже весь матеріал із центрів забору їде у єдину в місті лабораторію, тому краще чи гірше бути не може», – зазначає Галина Малиновська.

Аналізи вдома як укус комара
Здійснити забір аналізів можна також і вдома. Керівник клініко-діагностичної лабораторії «Сінево» розповідає, що в них є виїзна служба, куди можна зателефонувати, домовитись на ті день та годину, коли буде зручно та обговорити всі нюанси (номер квартири, код домофона). Медсестра приїжджає додому або в офіс, проводить забір матеріалу та оформляє його належним чином.
Забір проводиться одноразовими системами – вакутайнерами. Процедура відбувається надзвичайно швидко, навіть для маленьких дітей. Системи працюють під тиском і самі регулюють рівень крові, яку потрібно набрати. Голки дуже тонкі – їх майже не відчутно. Укол ними – немов укус комара.
Зберегти здоров’я і нерви
Львів’янка Катерина аналіз на глікований гемоглобін у звичайній поліклініці не може здати уже другий день поспіль. Пояснює: «Маю здати цей аналіз. Прийшла у поліклініку, потрібно, виявляється, скерування від лікаря. А її зараз немає, вона за кордоном. Перед маніпуляційним кабінетом черга, усі чхають-кашляють. Не хочу захворіти на грип чи іншу хворобу. Пішла додому ні з чим. Наступного дня те саме. Махну рукою і піду в будь-яку приватну лабораторію. І здоров’я збережу і нерви».

Мережа лабораторій «Сінево» входить до європейського медичного холдингу Medicover. До нього ж належить і Медичний центр Medicover у Львові. Для зручності пацієнтів у центрі працює власна клініко-діагностична лабораторія. Її завідувачка Ольга Чорненька розповідає, що пацієнти мають можливість отримати перелік обстежень та аналізів за максимально короткий час. Це особливо важливо для пацієнтів з інших областей. У лабораторії Medicover можна отримати загальний аналіз крові, сечі, дізнатися групу крові та рівень гормонів упродовж однієї години. Це дуже зручно, бо можна одразу ж, не виходячи з Медичного центру, отримати додаткові призначення лікаря, схему подальшого лікування.

У клініко-діагносточній лабораторії Медичного центру Medicover можна здати аналіз, економлячи час. Ви отримуєте із спеціального боксу номер своєї електронної черги, коли він з’являється на моніторі, можете заходити до маніпуляційного кабінету. Пацієнти отримують правила підготовки до аналізу, а найменші відвідувачі після маніпуляції ще й подаруночки: наклейки, безпечні іграшки та батончики гематогену.
«Наші пацієнти дуже люблять зручне крісло у маніпуляційній, діти обожнюють бізіборд, інколи так ним захоплюються , що забувають, що потрібно плакати», – усміхається Ольга Чорненька.
Лише у Medicover можна зробити картку групи крові із вашим фото, яке роблять на рецепції. Картка маленька і її зручно носити у гаманці.

Страхи і вподобання
Вирушаю для порівняння і в державну поліклініку. Тетяна працює лаборантом у державній поліклініці вже 20 років, про вподобання пацієнтів не говорить, більше про страхи. Розповідає, що діти плачуть, бо бачать як із кабінету виходять інші заплакані діти, яким щойно взяли аналіз, і вони бояться. У вагітних – страх не набратись грипу чи застуди від хворого, який чекає своєї черги. Та й не тільки у вагітних ті страхи: хтось боїться свідомість втратити, хтось – щоби синця на руці не залишилося.
Черга в клініко-діагностичній лабораторії поліклініки № 2, що на вулиці Симоненка, – чимала. Перевагою у порівнянні із приватними лабораторіями є те, що здати аналізи можна абсолютно безкоштовно. Недоліком – те, що доведеться постояти у черзі, а заздалегідь взяти скерування від лікаря. Маніпуляційна з ремонтом, світла, для забору крові не потрібно купувати вату та спирт, як це було раніше. Державні лабораторії цим забезпечені. Пацієнти, що очікують своєї черги, скаржаться на єдине – довге чекання, проте запевняють, що аналізи тут роблять швидко і якісно.
«Ніколи не забуду те відчуття, як у моїй руці голка шукає вену. Той страх до здачі крові із вени переслідував мене багато років, аж поки не пішла у приватну лабораторію і відчула, що все може бути інакше», – каже Ярина. «Коли палець у поліклініці пробивають так сильно і тиснуть з усієї сили, щоб крові було більше, а потім він болить кілька тижнів, це теж спогад незабутній, і в тебе зі страху перед тим аналізом всі руки спітнілі», – додає її подруга Інна.

Комфорт та швидкий доступ до результатів
У «Сінево» єдина база, тобто якщо ви здали аналізи у Львові, то зі своїм бланком замовлення або паспортом можете їх забрати, скажімо, в Сумах, чи іншому місті. База єдина, штрих-код єдиний і лише Ваш. Результати можна одержати як на електронну пошту, так і в будь-якому лабораторному центрі, або ж – зарєструвавшись в особистому кабінеті на сайті «Сінево». Коли ви реєструєтесь, отримуєте доступ до особистого кабінету на сайті «Вітаграмма», в якому зберігається вся історія результатів аналізів, і там завжди можна знайти цікаві пропозиції на аналізи зі знижками.
Результат на мобільному
І наостанок – про результат мандрівки моєї пробірки із кров’ю у «Сінево». А прийшов він оповіщенням про готовність результатів аналізів смс-кою на мій мобільний телефон, ну і самі результати одразу ж впали на електронну пошту. Результат – глікований гемоглобін в мене у нормі. А це – найважливіше.
Іванка Павлюк
Фото: Зиновій Няй
Читайте ще більше фахових порад і тематичних матеріалів у новому спецпроекті Tvoemisto.tv «Твоє здоров'я». Щотижня ми публікуємо тексти на актуальні теми, які найбільше цікавлять львів’ян. Генеральний партнер проекту — Медичний центр Medicover.

Повна або часткова републікація тексту без письмової згоди редакції забороняється і вважається порушенням авторських прав.





